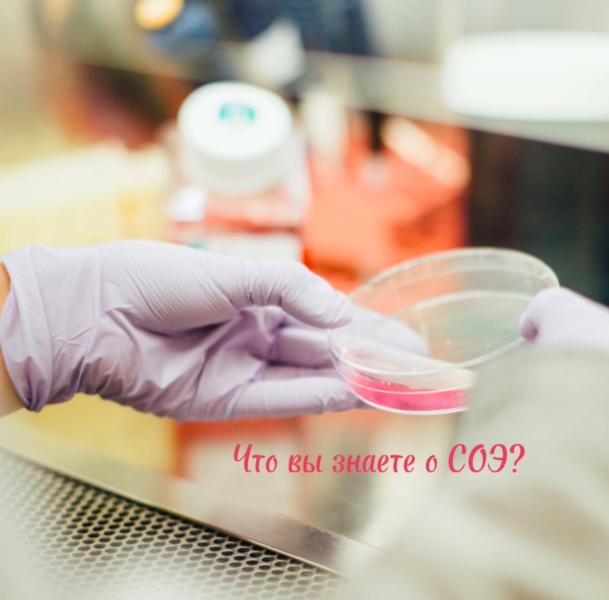

Давно не смотрела ни чего годного,и тут вот пожалуйста, первый сериал мистика,все как мы любим,второй психи и маньяки,и третий просто не плохой кинчик👌

Вижу, что по теме о вакцинации от ВПЧ у вас очень много вопросов.
Поэтому решила разобрать подробно:
✅ Какую защиту дает вакцинация?
✔️В первую очередь, это защита от дисплазии и рака шейки матки❗️
✔️Но! ВПЧ — это не только РШМ, также и другие ВПЧ-ассоциированные раки! Что важно и для мальчиков!
⠀
Относительно распространенности других видов злокачественных новообразований, вызываемых ВПЧ, согласно статистике:
▪️22,2 % приходится на орофарингеальный рак, затрагивающий полость рта, глотку и гортан...

Привет.👋
Я такая зануда стала, но спишем на возраст и/или опыт😂
Я сегодня про всякие кишечные истории хочу поговорить, потому что многие родители испытывают паническую атаку при повторных рвотах у ребенка. Да что уж, я тоже. Это раздражает, заставляет нервничать, находиться в постоянном напряжении и не всегда понятно как действовать и где тот момент, что нужна помощь специалистов.
Не буду разделять на возбудителей, назовем это просто ОКИ (острые кишечные инфекции), туда же ПТИ (пищевая токсико...



Боже храни того, кто посоветовал купить такую пасту для снятия налета с зубов. Справляется с задачей отлично. Пока в процессе, но уже прям виден результат. Ещё чистить, да чистить, а уже почти белые зубки)






Дочь укусил боррелиозный клещ 😫 Подробности в карусели.
Укусил под грудью. Из-за майки я заметила вечером. Он был маленький, не надувшийся, микро-клещ. Сам отцепился, когда майкой задела при снимании. У меня был с собой доксициклин, но в инструкции он значится с 8 лет. Я ничего не стала давать и забыла о нем…
Но через 7 дней появилось красное кольцо вокруг укуса, а в центре - белое. Стали наблюдать. Оно росло. Больше других признаков не было. Позвонила Куренкову. Он смог приехать только в во...

ЧТО ВЫ ЗНАЕТЕ О СОЭ?
⠀
📌СОЭ — это скорость оседания эритроцитов.
⠀
На сегодня это один из простых дешевых лабораторных тестов, представленных в общем анализе крови (ОАК).
⠀
🩸Что такое СОЭ?
Это универсальная реакция организма на любую патологию, свидетельствующая о наличии в организме нарушений белкового обмена.
⠀
СОЭ зависит от вязкости крови. Чем более «жидкая» кровь, тем быстрее и с большей скоростью «падают» эритроциты в пробирке. И наоборот.
⠀
⚡️Факторы, изменяющие СОЭ (т.е. повышение СОЭ пр...


РАК ЯИЧКА — редкое, но очень агрессивное заболевание.
⠀
Когда я училась в университете, на 3 курсе умер однокурсник от рака яичка, очень быстро сгорел…
⠀
🆘Рак яичка — заболевание молодых мужчин.
⠀
Пик основной заболеваемости приходится на 20-30 лет, чуть меньше случаев — на 30-40 лет. Это связано с определенными гормональными изменениями в организме.
⠀
Имеет значение несвоевременное опущение яичка или неопущение яичка во время внутриутробного развития и младенчестве, когда яичко из брюшной полос...
❗Алгоритм действий при укусе клеща от доказательных педиатров.
Что делать:
- Удалить клеща за носик (не за брюшко) тонким пинцетом, ниткой или специальным устройством для удаления клещей
- Сжечь клеща. Не раздавливать, не выбрасывать
- Промыть место укуса с мылом и обработать антисептиком
- Дать ребенку антибиотик Юнидокс Солютаб — из расчета 4,4 мг/кг однократно (но не более 200 мг). Насчет противопоказаний можно проконсультироваться с врачом. Если этот антибиотик ребенку нельзя, то никакой др...






Часто тут вижу просьбы расшифровать анализы до приема врача. СОХРАНИТЕ себе в телефон и живите спокойно 😂
Документ на 50 страниц , делюсь вырезками. Очень выручает 👍 в документе есть биохимия крови и много чего еще ! Я как то кидала по доброте душевной девочкам уже полный формат , если надо , ставьте плюс , я что-нибудь придумаю ) каждому пересылать сейчас у меня нет физически возможности , вас много 😭❤️
Скорее всего создам канал в телеге и туда скину , ссылку оставлю в комментариях. Если есть и...

Можно я вам о высокой температуре расскажу? Ну, на правах работника детской реанимации, а не многодетной матери🤣
Просто сужу по себе, если я понимаю механизм чего-либо, то мне становится гораздо спокойнее.
Я не в силах всем ответить, буду стараться. По все вопросам можно тут найти ответы ссылка
Лихорадка, высокая температура – моя любимейшая тема.
Итак, что такое температура? Шокирую – повышение температуры тела это хорошо. (Так же, как и кашель – это прямо др...